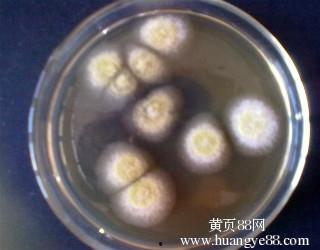

你知道吗?在神秘而古老的东方,有一种神奇的真菌,它不仅在日本有着悠久的历史,更是日本独有的一种宝贝。它就是——米曲霉!今天,就让我带你一起探索这个小小的真菌,看看它如何在日本的大地上绽放光彩。
米曲霉:日本独有,历史悠久

米曲霉,学名为Aspergillus oryzae,是一种广泛用于食品发酵的真菌。它起源于我国,后来传入日本,成为了日本饮食文化中不可或缺的一部分。据史料记载,早在公元7世纪,日本就已经开始使用米曲霉进行食品发酵了。
在日本,米曲霉被尊称为“米の神”,象征着丰收和吉祥。它不仅在日本的传统食品中扮演着重要角色,如酱油、味噌、清酒等,还广泛应用于医药、化工等领域。
米曲霉:食品发酵的魔法师
米曲霉的神奇之处在于,它能够将谷物中的淀粉转化为糖分,再通过发酵产生各种风味物质。这种独特的发酵过程,使得日本的传统食品独具特色。
1. 酱油:酱油是日本饮食文化中不可或缺的调味品。米曲霉在酱油的发酵过程中发挥着关键作用,它能够将大豆中的蛋白质转化为氨基酸,使酱油味道鲜美。
2. 味噌:味噌是日本传统的调味品,由大豆、米曲霉和盐发酵而成。米曲霉在味噌的发酵过程中,不仅能够产生独特的味道,还能增加营养价值。
3. 清酒:清酒是日本的传统酒类,以大米为原料,经过米曲霉的发酵而成。米曲霉在清酒的发酵过程中,能够产生丰富的香气和口感。
米曲霉:医药界的守护者

除了在食品发酵领域的广泛应用,米曲霉在医药领域也有着举足轻重的地位。
1. 抗生素:米曲霉能够产生多种抗生素,如青霉素、头孢菌素等。这些抗生素在治疗细菌感染方面发挥着重要作用。
2. 生物制药:米曲霉在生物制药领域也有着广泛应用,如生产胰岛素、干扰素等。
米曲霉:日本文化的传承者
米曲霉不仅仅是一种真菌,更是日本文化的传承者。在日本,米曲霉的发酵过程被视为一种艺术,许多日本家庭都会在家庭中制作酱油、味噌等食品。
此外,米曲霉还与日本的节日文化密切相关。在日本的传统节日中,人们会制作各种米曲霉食品,如年糕、馒头等,以此祈求新的一年平安、健康。
米曲霉:未来发展的新方向
随着科技的不断发展,米曲霉的研究和应用也在不断拓展。如今,科学家们正在研究如何利用米曲霉生产更多具有营养价值和药用价值的物质。
例如,研究人员正在尝试利用米曲霉生产新型抗生素,以应对日益严重的抗生素耐药性问题。此外,米曲霉在生物燃料、生物降解材料等领域的应用也备受关注。
米曲霉这种小小的真菌,在日本的大地上绽放着独特的光彩。它不仅为日本人民带来了美味的食品,还在医药、化工等领域发挥着重要作用。相信在未来的日子里,米曲霉将继续为人类的生活带来更多惊喜。